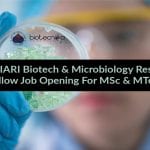
ICAR-IARI Biotech / Microbiology Research Fellow Job Opening ICAR-IARI Biotech / Microbiology
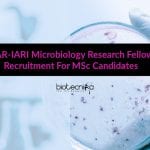
ICAR-IARI Microbiology Research Fellow Recruitment For MSc Candidates ICAR-IARI Microbiology Research Fellow

Home Search
biology - search results
If you're not happy with the results, please do another search
Japanese Government [MEXT] Scholarship Program 2020 For Biotech & Biology
Japanese Government Scholarship 2020 For Biotech & Biology
The Japanese Ministry of Education, Culture, Sports, Science and Technology (MEXT), through Embassy of Japan, New...
Syngene Research Associate Molecular Biology Job Opening
Syngene Research Associate Molecular Biology Job Opening
Syngene Research Associate Molecular Biology Job Opening. Syngene MSc/MTech Life Sciences Senior Research Associate-Molecular Biology Job. Check the...
MACS ARI Pune Developmental Biology Group SRF Job Opening
MACS ARI Pune Job - Biotech & Biochem SRF Vacancy
MACS ARI Pune Job - Biotech & Biochem SRF Vacancy. MSc Biotechnology / Biochemistry &...
Govt HPSSC Recruitment – M.Sc / B.Sc Biotech / Microbiology Apply
Govt HPSSC Recruitment - M.Sc / B.Sc Biotech / Microbiology Apply
Govt HPSSC Recruitment - M.Sc / B.Sc Biotech / Microbiology Apply. Himachal Pradesh Public...
ICAR-NRRI Biotech / Microbiology / Life Science Research Fellow Job
ICAR-NRRI Biotech / Microbiology / Life Science Research Fellow Job
ICAR-NRRI Biotech / Microbiology / Life Science Research Fellow Job. MSc Biotechnology / Life Sciences/...
ICAR-IARI Biotech / Microbiology Research Fellow Job Opening
ICAR-IARI Biotech / Microbiology Research Fellow Job Opening
ICAR-IARI Biotech / Microbiology Research Fellow Job Opening. MSc Biotechnology & Microbiology / MTech Biotech Jobs. MSc/MTech...
TANUVAS Research Fellow Job For Biotech / Microbiology / Zoology Candidates
TANUVAS Research Fellow Job For Biotech / Microbiology / Zoology Candidates
TANUVAS Research Fellow Job For Biotech / Microbiology / Zoology Candidates. BSc candidates are...
Syngene Bioinformatics & Computational Biology Associate Job
Syngene Bioinformatics & Computational Biology Associate Job
Syngene Bioinformatics & Computational Biology Associate Job. Syngene Bioinformatics, Computational Biology Research Associate Jobs. Check the details on...
National Health Mission Microbiology Job With Rs. 60,000 Salary pm
NHM Microbiology Job With Rs. 60,000 Salary pm
NHM Microbiology Job With Rs. 60,000 Salary pm. National Health Mission Job Openings. MSc & PhD Microbiology...
IISER Bhopal Life Science / Cell Biology / Genetics Research Vacancy
IISER Bhopal Life Science / Cell Biology / Genetics Research Vacancy
IISER Bhopal Life Sciences / Cell Biology / Genetics Research Vacancy. IISER Bhopal -...
ICAR-IARI Molecular Biology & Genetics Research Fellow Job
ICAR-IARI Molecular Biology & Genetics Research Fellow Job
ICAR-IARI Molecular Biology & Genetics Research Fellow Job. MSc Plant Physiology/ Molecular Biology/ Biotechnology/Genetics/Biochemistry /Botany or relevant...
PAU Molecular Biology & Biotechnology Student Fellow Leading to PhD Opportunity
PAU Mol Biology & Biotech Student Fellow Leading to PhD Opportunity
PAU Mol Biology & Biotech Student Fellow Leading to PhD Opportunity. Research Job Openings....
CSIR-CSMCRI Life Sciences & Microbiology Research Associate Job
CSIR-CSMCRI Life Sciences & Microbiology Research Associate Job
CSIR-CSMCRI Life Sciences & Microbiology Research Associate Job. CSIR-CSMCRI recruiting for research associate post. CSIR-Central Salt and...
Syngene Freshers Microbiology Vacancy – Executive Job Opening
Syngene Freshers Microbiology Vacancy - Executive Job Opening
Syngene Freshers Microbiology Vacancy - Executive Job Opening. Syngene Microbiology Executive Jobs. Check the details on the...
ICAR-IARI Microbiology Research Fellow Recruitment For MSc Candidates
ICAR-IARI Microbiology Research Fellow Recruitment For MSc Candidates
ICAR-IARI Microbiology Research Fellow Recruitment For MSc Candidates. MSc Applied Microbiology Jobs. MSc candidates can apply for...


















![Japanese Government [MEXT] Scholarship Program 2020 For Biotech & Biology Japanese Government [MEXT] Scholarship](https://www.biotecnika.org/wp-content/uploads/2020/06/Japanese-Government-MEXT-Scholarship-150x150.jpg)